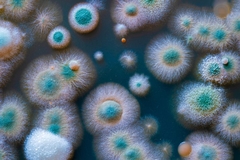
Mold Menaces: How to Spot and Safeguard Your Space from Hidden Health Hazards

Have you ever experienced a mysterious smell that never seemed to go away or spotted dark spots creeping along your walls? These could be signs of mold infestation, a common yet often overlooked household hazard. Mold growth in homes isn't just unsightly-it's a stealthy invader that can wreak havoc on both your health and property. As homeowners become more cognizant of indoor air quality and its effects on health, understanding how to identify and combat mold becomes crucial.
Within the bustling sphere of emergency restoration services in Louisville and its nearby areas, Purofirst Disaster Services stands as a reliable damage restoration company, ready to address the pervasive threats of mold infestation. With a deep understanding of property damage issues, we present you with essential insights and actionable advice on dealing with mold-the villain hiding in plain sight.
Understanding Mold and Its Impact
Mold is a type of fungus that thrives in moist environments, commonly found in bathroom corners, basements, and any area that experiences frequent water exposure. Invisible to the naked eye initially, mold can grow and spread rapidly, making early detection paramount. Beyond the visible signs, mold can contribute to poor air quality and pose significant health risks, particularly for individuals with respiratory issues, allergies, or weakened immune systems.
Common Sources of Mold Infestation
Mold spores are omnipresent, and under the right conditions-such as humidity levels above 60%-these spores can settle and grow into colonies. Key contributors to mold infestation include:
- Water Leaks: Leaky roofs, faulty plumbing, and improperly sealed windows are prime sites for mold growth.
- Poor Ventilation: Without adequate airflow, moisture from daily activities like cooking and showering can accumulate, leading to mold-friendly environments.
- Flood Damage: Even a minor flood can create the perfect breeding ground for mold if not addressed promptly with professional restoration services.
Signs Your Home May Be Harboring Mold
Recognizing early signs of mold can save you from costly damage restoration services down the line. Here are some indicators that your home might be under attack:
- Musty Odors: A persistent earthy or damp smell often suggests hidden mold.
- Visible Growth: Black, green, or white spots appearing on walls, ceilings, or around fixtures can be a direct mold indication.
- Health Symptoms: Increased respiratory problems, sneezing, and eye irritation could signal mold in your environment.
Advanced Detection Techniques
When the presence of mold isn't evident, employing advanced detection methods can help. Professional mold removal and remediation services often include:
- Air Quality Testing: Measures airborne spore concentrations to assess mold presence.
- Infrared Scanning: Detects moisture behind walls, floors, and ceilings, indicating hidden mold issues.
DIY Mold Prevention Tips
Preventing mold is often easier and more cost-effective than dealing with an established problem. Consider these strategies to safeguard your home:
- Control Humidity: Use dehumidifiers to maintain indoor humidity below 60%.
- Improve Ventilation: Install exhaust fans in bathrooms and kitchens to reduce moisture build-up.
- Regular Maintenance: Inspect plumbing for leaks and keep gutters clean to prevent water infiltration.
- Use Mold-Resistant Products: Opt for mold-resistant drywall and paints in areas prone to dampness.
When to Call in the Experts
Despite best efforts, mold can sometimes take hold deep in materials, making professional intervention necessary. Mold removal and remediation in the Louisville area becomes imperative under such circumstances. Trained experts can effectively eradicate mold using specialized techniques that go beyond surface cleaning.
Benefits of Professional Mold Remediation
- Thorough Inspection: Comprehensive assessment to locate all mold sources.
- Safe Removal: Use of proper containment and safety measures to prevent further spread.
- Preventive Measures: Application of treatments to prevent future mold growth.
The Hidden Costs of Ignoring Mold
Ignoring mold doesn't just risk escalating remediation costs, but also impacts your home's value and, more importantly, your family's health. Potential consequences include:
- Structural Damage: Mold can weaken walls and foundations over time.
- Medical Expenses: Unaddressed mold exposure can lead to chronic health issues requiring medical attention.
- Decreased Property Value: Homes with visible mold problems can be difficult to sell and attract lower offers.
Take Immediate Action Today
Mold is more than a mere nuisance; it's a genuine health hazard that demands prompt attention. As a trusted partner for emergency restoration services, Purofirst Disaster Services is committed to providing effective solutions. Whether you need storm damage restoration in Lyndon and its surrounding areas to prevent mold infestation or direct mold removal and remediation in New Albany, our experts can deliver quality service in these areas with unwavering dedication.
If you suspect mold presence in your home, don't wait for it to grow out of control. Contact us today for professional assistance in mold removal and remediation in Louisville and beyond. Safeguard your health and property by addressing mold problems decisively and effectively. By ensuring your living space is free of mold, you create a healthier environment for yourself and your family.